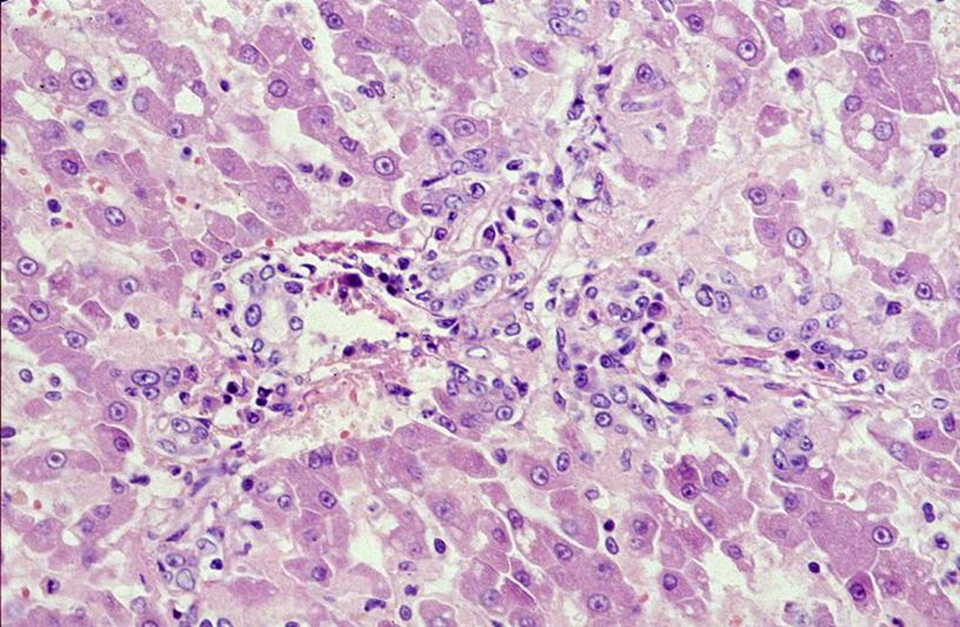

1/40
Looks like no tags are added yet.
Name | Mastery | Learn | Test | Matching | Spaced | Call with Kai |
|---|
No analytics yet
Send a link to your students to track their progress
What is being shown here?

Absence of liver lobe (aplasia of the left lobe)
Not likely to have clinical sings
Can also get supernumerary lobes
What congenital defect is being shown here?

Bovine, aborted fetus, liver: congenital cysts
If calf had been born liver function may have been compromised
What is being shown here?

Polycystic kidney syndrome
Inherited disease (autosomal dominant)
What are the different congenital portosystemic vascular shunts?
What breed of dog are each of them seen in?
How do you treat them?
Intrahepatic shunt: due to persistence of fetal ductus venosus (large breed dogs)

extrahepatic shunt:due to direct connections between portal vein and vena cava / azygous vein (small breed dogs and cats)

can treat surgically
What is the ductus venosus?
Fetal connection between left umbilical vein (portal vein) and caudal vena cava
What will be seen grossly and histologically with congenital portosystemic vascular shunts?
gross
small liver
histology
small hepatocytes
small / absent portal veins in triads
reduplication of arterioles in triads
Describe what is being shown here?

Liver is small in relation to the stomach
Pale due to lack of blood supply
What is being shown here?

Diaphragmatic hernia
Common in cats following RTA
What is being show here?
Which lobe is most predisposed to this?

Torsion of one liver lobe
Occludes the blood supply and the lobe becomes necrotic
Left lateral lobe is predisposed (most mobile), but torsion is rare.
Haemorrhagic shock > death
What is being shown here and what causes it?

Rupture
blunt trauma (e.g. road traffic accidents)
alterations in parenchyma (e.g. amyloidosis - shown in image, lipidosis) - more friable
neoplasms (e.g. haemangiosarcoma)
What does acute congestion in the liver cause?
Pressure will spread from the hepatic lobule to the portal area
Acute cardiovascular failure (i.e. agonal)
Anaphylaxis
Shock
What occurs with chronic congestion?
Increased venous pressure (due to red CO)
Ascites
Hydrothroax
What is seen grossly with nutmeg liver?
slightly nodular and rough surface(irregular outlines of the liver)
ascites, fibrin deposition
pooling of blood (due to congetsion)


What will be seen histologically with nutmeg liver?
centrolobular necrosis
fibrosis around central vein
Describe how acquired extrahepatic porto-systemic shunts occur?
hepatic fibrosis and/or cirrhosis
development of portal hypertension
dilation of (non-functional) veins between portal vein (or veins which terminate in the portal vein) and caudal vena cava
What is being shown here?

Dilated tortuous blood vessels
Can't treat surgically due to multiple vessels and underlying liver issue
What is being shown here and what species is it usually in?

Teleangiectasis = dilation of functional blood vessels (not clinically releavant)
Cattle and cats
What is being shown here and what species is it in?

peliosis hepatis = irregular blood-filled cystic spaces in the liver parenchyma
mainly in cats
What is being shown here?

Degeneration of hepatocytes
“Cloudy swelling” or hydropic (water) degeneration
What causes hepatocyte degeneration?
Non-specific change (e.g. toxins, metabolic insults, hypoxia, cholestasis)
Reversible
What causes atrophy of hepatocytes?
pressure from other internal organs
Chronically distended right dorsal colon (same can occur with distended rumen)

reduced blood supply (e.g. shunt)
What are the different types of lipidosis of the liver?
Nutritional lipidosis
excessive release of free fatty acids from adipose tissue (peak lactation and parturition)
Hypoxic lipidosis
Toxic lipidosis
What clinical scenarios would pre-dispose different species to hepatic lipidosis?
Peak lactation in cattle
Twin lamb disease in sheep
Obese pony that gets muzzled (sudden change in diet)
Onset of colic - sudden decrease in eating/ feed restriction
Cat being stuck somewhere
What is being shown here?


Lipidotic liver
Large - rounded edges to the lobes
Yellow
Friable
What is being shown in this liver with lipidosis?
How do you confirm it is lipidosis?


Large clear vaculoses
Nucleus to the side (dif to degeneration)
Oil Red O stain
What can cause hyperlipidaemia?
with diabetes mellitus, pancreatitis, hypothyroidism, hyperadrenocorticism
with high dietary fat intake
equine hyperlipidaemia, feline idiopathic hepatic lipidosis
What causes ketosis?
with starvation, diabetes mellitus, pregnancy, lactation
Sheep; pregnancy toxaemia “twin lamb disease”
What is Hypoglycaemia and fatty liver syndrome seen with?
Small dog breeds
Low capacity for gluconeogenesis from muscle protein as small muscle mass; anorexia due to stress (infection, vaccination)
What can excess glucocorticoids cause in the body?
Decreased lipogenesis
Increased lipolysis of adipose tissue
Increased catabolism of skeletal muscle protein
Increased gluconeogenesis in the liver (↑ glycogen stores)
What is being shown here?

Focal lipidosis due to tension from the ligament
Incidental finding
When would glycogen accumulate in the liver?
Abnormal glucose or glycogen metabolism
Diabetes mellitus
Glycogen storage diseases (genetic)
Steroid-induced hepatopathy (dogs)
exogenous/iatrogenic
Cushing’s disease (hyperadrenocorticism)
How would we confirm it is glycogen on histology?
PAS stain

Where is amyloid usually deposited?
Between cells (in space of Dissé and sinusoids)
What type of amyloid will be deposited?
Usually AA (amyloid-associated):
Synthesised in hepatocytes
Usually systemic (generalised): deposition in several organs
What is being shown here?

Diffuse amyloidosis and ruptures
Pale orange/tan, enlarged, rounded edges
What is being shown here?
Amyloidosis
Accumulation of eosinophilic material BETWEEN cells
What is being shown here?

Hepatic melanosis
Not clinically significant
What is Haemochromatosis?
Hepatic haemosiderin accumulation due to increased iron uptake
What stain would you use to identify iron?
Perl’s Prussian blue stain

What is photosensitisation caused by?
Defective pigment synthesis
Intoxication
St. John`s wort (Hypericum perforatum)
Buckwheat (Fagopyrum spp.)
Spring parsley (Cymopterus watsoni)
What are the clinical signs associated with defective pigement synthesis?
Reddish-brown pigment deposition in dentin and bone (pink teeth) and liver, excretion with urine
Skin lesions develop because uroporphyrins absorb UV-A radiation reactive O2 species
